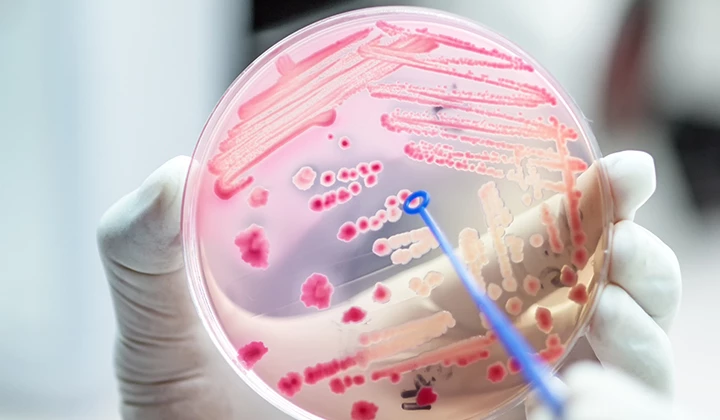

Darmflora-Aufbau nach Antibiotika
Begleitende Maßnahmen im Kampf gegen Bakterien
Geschätzte Lesedauer: 2 Min.
Bei einer bakteriellen Erkrankung stellt die Einnahme von Antibiotika ein probates Mittel dar. Allerdings kann durch Antibiotika im Darm das empfindliche Wachstum unserer Mikroorganismen gestört werden. Dann ist die Verdauungstätigkeit in Gefahr, durcheinanderzugeraten und manchmal siedeln sich unerwünschte Bakterien oder Pilze im Verdauungskanal an.
Je nachdem, wie stark die Darmflora nach Antibiotika-Einnahme beeinträchtigt ist, kommen verschiedene Strategien zur Wiederherstellung der Darmgesundheit in Betracht.
Warum die Darmflora aufbauen nach Antibiotika?
Ein Antibiotikum soll unserem Körper dann helfen, wenn er durch Bakterien und andere Mikroorganismen ausgebremst wird. Das Antibiotikum hemmt das Wachstum dieser Erreger oder tötet sie sogar ab. Gegen Virusinfektionen sind Antibiotika hingegen unwirksam.
Warum ist es aber sinnvoll, den Wiederaufbau der Darmflora nach der Antibiotika-Einnahme zu unterstützen? Da Antibiotika nicht nur die bakterielle Infektion bekämpfen, sondern auch „gute“ Bakterien im Darm angreifen, kann unsere Darmflora aus dem Gleichgewicht kommen.
Wie den Darmflora-Aufbau nach Antibiotika unterstützen?
Gesunde und ballaststoffreiche Ernährung
Ein Weg, um eine schnelle Erholung der Darmflora nach Antibiotika-Einnahme zu unterstützen, führt über die Ernährung. Eine vollwertige Kost – schon während der Erkrankung – mit naturbelassenen Mehlen, Haferflocken und Milchprodukten wie Joghurt und Kefir kann dafür die Grundlage sein.
Begleitende Kur zur Antibiotika-Einnahme
Häufig reicht eine Ernährungsumstellung eventuell nicht aus. Hier kann unter Umständen eine sich gegebenenfalls über mehrere Wochen erstreckende Kur mit Nahrungsergänzungsmitteln aus Probiotika und Präbiotika zu empfehlen sein. Bei ersteren handelt es sich um Mikroorganismen, bei Letzteren um unverdauliche, aber wichtige Ballaststoffe.
Zweifelhaft: Die Darmsanierung
Dieser Begriff wird häufig von Heilpraktikern im Zusammenhang mit einer gestörten Darmflora benutzt. Bei einer Darmsanierung soll eine Reinigung und Entgiftung des Darmes erfolgen. Man glaubt, mit einer solchen Anwendung Giftstoffe und Ablagerungen zu entfernen, um unerwünschten Darmbakterien die Nahrungsgrundlage zu entziehen. Wissenschaftlich ist ein solcher Effekt allerdings nicht belegt.
Die regenerierte Darmflora nach Antibiotika-Einnahme erhalten

Wenn Sie Ihre Darmflora nach Antibiotika-Einnahme regenerieren konnten, merken Sie dies an einer wieder normalisierten Verdauungstätigkeit. Fortwährend kann hier eine dauerhafte Ernährungsumstellung einen großen Einfluss spielen. Einige Lebensmittel haben dabei eine nachteilige Wirkung auf die Darmflora. Folgend finden Sie auszugsweise eine Aufstellung der Lebensmittel, welche die Darmgesundheit negativ beeinflussen können und nebenbei auch dem Darmflora-Aufbau nach Antibiotika abträglich sind:
Alkohol
Schon aus Gründen der allgemeinen Gesundheitsvorsorge ist es empfehlenswert, den Konsum alkoholischer Getränke auf ein Minimum zu beschränken. Als Faustregel gilt, dass Männer nicht mehr als 0,5 Liter Bier oder 0,25 Liter Wein pro Tag zu sich nehmen sollten, Frauen wiederum die Hälfte dieser Werte. Da Alkohol die Darmflora schädigt, sollte im Idealfall eine Zeit lang gänzlich auf Alkohol verzichtet werden, um den Darmflora-Aufbau nach Antibiotika-Therapie zu unterstützen.
Fleisch
Pökelsalz (Nitrate und Nitrite) werden seit alters her zum Haltbarmachen von Wurst- und Fleischwaren eingesetzt. Grundlage dafür ist die Erkenntnis, dass die Salze abtötend auf Bakterien wirken. Möglicherweise kann sich daher auch der Verzehr gepökelter Produkte negativ auf die Darmflora auswirken.
Zucker
Auch Zucker bietet für schädliche Pilze und Bakterien die Nahrungsgrundlage und sollte somit ebenfalls so gut wie möglich beim Aufbau der Darmflora nach Antibiotika reduziert werden. EiDie Darmflora und die Darmschleimhaut können sich verändern oder es kann sogar eine Funktionseinschränkung entstehen.
Quellen:
Journal Magazin: http://journalmedizin.de/
Int.J.Mol.Sci 21,2020
Science, 2012
Bundesprogramm ökologischer Landbau (2008): Untersuchungen zur mikrobiologischen Wirksamkeit von Natriumnitrat bei Rohwursterzeugnissen.
Weitere interessante Artikel